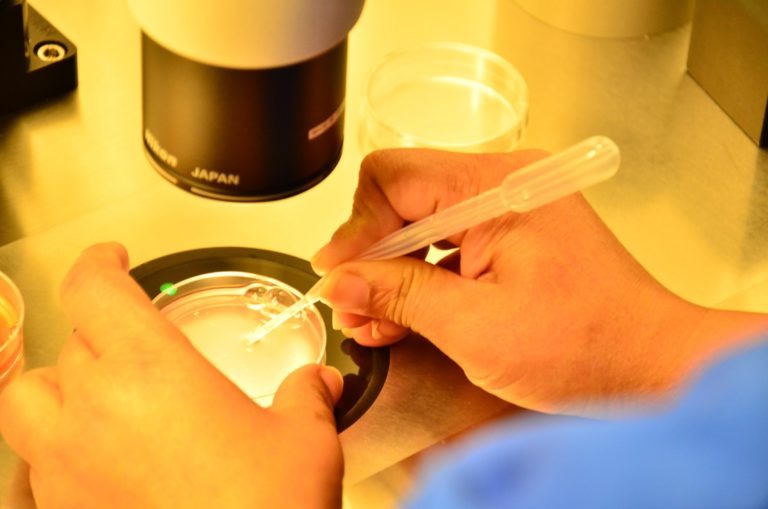

ICSI Treatment in PCMC
It’s a micromanipulation technique used in IVF that includes inserting a single sperm into the center of a mature oocyte while under a microscope.
Dr. Kalyani Ingale is the Best IVF Doctor in PCMC. She has 13 years of experience and has completed MBBS, DGO, DNB, Fellowship in Embryology, Infertility Specialist, Gynecologist, and Obstetrician. Ya conent sathi apn kashi desgin karu shakto elementor ne maze cha content dobt mala images deu shakto ka ki tuza desgin as kar

- Tubal disease symptoms include tubal blockages, rigid, oedematous tubes, and convoluted tubes
- Hydrosulpine
- Oligo-astheno-zoospermic
- Reduced ovarian reserve
- Endometriosis Stages III and IV
- Several IUI
- Embryo donation / oocyte donation
- Azoospermia (obstructive / non-obstructive)
- Genetic testing before implantation
- Multiple follicular development stimulation
- Monitoring
- follicular development and growth
- Follicular maturation trigger
- Recovery and identification of oocytes
- Insemination
- Culture of embryos
- Replacing an embryo
- Luteal phase assistance
- Pregnancy confirmation
GnRH-a should be started on day 21 of a normal menstrual cycle.
A serum progesterone level of >4 ng/ml or the existence of a corpus luteum on a transvaginal scan confirms the luteal start.
The risk of ovarian cyst formation is reduced by initiating GnRH-a in the luteal phase.
10–12 days following GnRH-a administration, expect spontaneous menses.
Transvaginal scan to assess endometrial lining after menses began and serum estradiol to confirm down-regulation before initiating gonadotropin stimulation (rec-FSH, or urinary FSH or combination).
The number and size of follicles, as well as the development of the endometrium and its shape, are all monitored with serial ultrasonography and E2 levels.
Rec-hCG, typically 5000–10,000 IU, should be given once the follicular size reaches 18–22 mm.
On day 2/3 of the period after oral contraceptive pretreatment, a transvaginal ultrasound and serum E2 are scheduled.
SC rec-FSH is started daily for ovarian stimulation after confirmation of sluggish ovaries and low E2 levels.
The GnRH antagonist 0.25 mg daily is then given as a set protocol beginning on day 6 of the stimulation and continuing until the day of HCG injection.
When leading follicles reach 18–20 mm and at least three mature follicles (16 mm) are seen on ultrasound examination, ovulation is triggered by a subcutaneous injection of 10,000 IU of hCG.
This is followed by oocyte retrieval using transvaginal ultrasound 34–36 hours later.
GnRH-a 0.05 mg/day starting on day 2 of the cycle.
Rec-FSH begins on day three.
GnRH agonist is given subcutaneously daily until human chorionic gonadotropin (HCG) is given.
When the leading follicle reaches 17–18 mm in diameter, a total of 10,000 units of rec-hCG 250 mcg is injected SC, followed by ultrasound-guided transvaginal oocyte retrieval 34–36 hours later.
Tifitacation
GnRH-a 0.05 mg/day starting on day 2 of the cycle.
Rec-FSH begins on day three.
GnRH agonist is given subcutaneously daily until human chorionic gonadotropin (HCG) is given.
When the leading follicle reaches 17–18 mm in diameter, a total of 10,000 units of rec-hCG 250 mcg is injected SC, followed by ultrasound-guided transvaginal oocyte retrieval 34–36 hours later.
Tifitacation
On day one of oocyte recovery, an oocyte is implanted under general anesthesia or intravenous sedation in a surgery theatre under ultrasound supervision.
The patient is washed and draped before being placed in lithotomic posture. The transvaginal probe with a needle guide is placed into the vagina to visualize both ovaries and follicles.
The needle is placed under ultrasound guidance into the first follicle of the lower, more accessible ovary. The follicular fluid is aspirated into a test tube heated in a warming block and handed to the embryologist in the adjacent IVF lab.
After aspirating all follicles on one side, the needle is removed and flushed with warm culture medium.
Before completion of surgery, the vagina is cleaned with sterile gauze swabs and hemostasis is confirmed. The patient is observed in recovery and discharged after 2–6 hours.
The embryologist examines the follicular fluid under a binocular microscope for the oocyte cumulus complex (OCC). The OCC is transferred to buffered medium, washed three times, and placed in a culture dish until insemination.
The husband’s semen sample is processed on the morning of oocyte retrieval. Density gradient technique followed by washing in culture medium is commonly used.
Fertilization is achieved either by insemination or ICSI, performed 4 hours post oocyte retrieval.
Insemination is done for patients with high sperm count and normal morphology.
ICSI is done for patients with poor sperm quality, anti-sperm antibodies, or previous fertilization failure.
Each mature oocyte is injected with one sperm.
18 hours after insemination or ICSI, fertilization is checked by confirming the presence of two pronuclei.
- Day 2: Four-cell stage
- Day 3: Eight-cell stage
- Day 4: Compaction
- Day 5–6: Blastocyst stage
High-quality embryos have regular blastomeres with no fragmentation.
Average-quality embryos have moderate fragmentation.
Poor-quality embryos have uneven blastomeres with many fragments.
Embryo development and grading criteria remain the same as described above. Embryos are selected based on quality before transfer.
IVF treatment success is mostly determined by embryo quality and endometrial receptivity.
Endometrial receptivity depends on adequate sub-endometrial blood flow and endometrial thickness.
Minimal ovarian stimulation or embryo vitrification followed by frozen embryo transfer improves IVF success rates.
